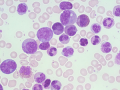
How targeted therapies are boosting outcomes for bone marrow cancer - Hindi News | How targeted therapies are boosting outcomes for bone marrow cancer | Latest health News at Lokmattimes.com

Goteborg [Sweden], September 30 : One novel approach to treating type 1 diabetes may involve blocking the somatostatin hormone ... ...

![MP Guv bats for eradication of sickle cell disease - Hindi News | MP Guv bats for eradication of sickle cell disease | Latest health News at Lokmattimes.com MP Guv bats for eradication of sickle cell disease - Hindi News | MP Guv bats for eradication of sickle cell disease | Latest health News at Lokmattimes.com]()
Bhopal, Sep 30 Madhya Pradesh Governor Mangubhai Patel said on Monday that medical counselling regarding sickle cell disease ... ...
![Kenya rolls out polio vaccination drive - Hindi News | Kenya rolls out polio vaccination drive | Latest health News at Lokmattimes.com Kenya rolls out polio vaccination drive - Hindi News | Kenya rolls out polio vaccination drive | Latest health News at Lokmattimes.com]()
Nairobi, Sep 30 Kenya's Ministry of Health on Monday announced a five-day vaccination campaign targeting 3.84 million children ... ...
![Rwanda traces Marburg virus closely as deaths hit eight - Hindi News | Rwanda traces Marburg virus closely as deaths hit eight | Latest health News at Lokmattimes.com Rwanda traces Marburg virus closely as deaths hit eight - Hindi News | Rwanda traces Marburg virus closely as deaths hit eight | Latest health News at Lokmattimes.com]()
Kigali, Sep 30 Rwandan authorities said they are closely monitoring up to 300 individuals identified as contacts of ... ...
![Rwanda traces Marburg virus closely as deaths hit eight - Hindi News | Rwanda traces Marburg virus closely as deaths hit eight | Latest health News at Lokmattimes.com Rwanda traces Marburg virus closely as deaths hit eight - Hindi News | Rwanda traces Marburg virus closely as deaths hit eight | Latest health News at Lokmattimes.com]()
Kigali, Sep 30 Rwandan authorities said that they are closely monitoring up to 300 individuals identified as contacts ... ...
![Why gynaecological cancers are rising among young Indian women - Hindi News | Why gynaecological cancers are rising among young Indian women | Latest health News at Lokmattimes.com Why gynaecological cancers are rising among young Indian women - Hindi News | Why gynaecological cancers are rising among young Indian women | Latest health News at Lokmattimes.com]()
New Delhi, Sep 30 Obesity, diabetes, and Polycystic Ovarian Syndrome (PCOS) are the key reasons why India is ... ...
![How targeted therapies are boosting outcomes for bone marrow cancer - Hindi News | How targeted therapies are boosting outcomes for bone marrow cancer | Latest health News at Lokmattimes.com How targeted therapies are boosting outcomes for bone marrow cancer - Hindi News | How targeted therapies are boosting outcomes for bone marrow cancer | Latest health News at Lokmattimes.com]()
New Delhi, Sep 30 Patients with chronic myeloid leukaemia (CML) -- a type of cancer of the bone ... ...
![Indian pharma companies to expand revenues by 9-11 pc in FY25 - Hindi News | Indian pharma companies to expand revenues by 9-11 pc in FY25 | Latest health News at Lokmattimes.com Indian pharma companies to expand revenues by 9-11 pc in FY25 - Hindi News | Indian pharma companies to expand revenues by 9-11 pc in FY25 | Latest health News at Lokmattimes.com]()
New Delhi, Sep 30 The Indian pharma companies are estimated to expand their revenues by a healthy 9-11 ... ...
![Healthcare sector at forefront of nanotechnology innovation: Report - Hindi News | Healthcare sector at forefront of nanotechnology innovation: Report | Latest health News at Lokmattimes.com Healthcare sector at forefront of nanotechnology innovation: Report - Hindi News | Healthcare sector at forefront of nanotechnology innovation: Report | Latest health News at Lokmattimes.com]()
New Delhi, Sep 30 Healthcare industries are pioneering nanotechnology innovation with use in diagnostics, drug delivery, and medical ... ...
![Bangladesh records highest daily dengue cases - Hindi News | Bangladesh records highest daily dengue cases | Latest health News at Lokmattimes.com Bangladesh records highest daily dengue cases - Hindi News | Bangladesh records highest daily dengue cases | Latest health News at Lokmattimes.com]()
Dhaka, Sep 30 A total of 1,221 people were diagnosed with dengue fever in Bangladesh the highest number ... ...